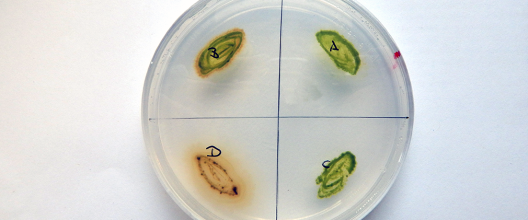

AP 5: Direct effect of Plastic particles on Invertebrates
Contact
Prof. Dr. Walter Traunspurger
Universität Bielefeld, Abteilung Tierökologie, Konsequenz 45, 33615 Bielefeld
E-Mail: traunspurger@uni-bielefeld.de
Project Partner
Universität Münster, Universität Potsdam, Ecossa, Mesocosm GmbH
Abstract
Respiration- and Growth-rates of biofilms on various polymers will be investigated under aerobe and anaerobe conditions, as well as in light-exposed and non-exposed microcosms. To gain reproducible biofilms on polymers for usage in sedimentation- (AP2) and grazing-assays (AP6), pre-experiments will be conducted under varying environmental conditions with isolated bacterial strains and indigenous flora from the respective sampling spots.
Effects of ingested microplastics are going to be assessed in single-species laboratory experiments with pelagic and benthic organisms, and by more complex model-ecosystems respectively: Initially, ingestion rates of relevant cultivated zooplanktonic organisms (Crustacea: Daphnia magna, Rotatoria: Brachionus calyciflorus, Keratella cochlearis), meiobenthic organisms (Nematoda: Cae- norhabditis elegans; Pristionchus pacificus) and macrobenthic organisms (Crustacea: Gammarus roeselii, Gastropoda: Radix balthica) on defined plastic particles with various sizes and conditions (as identified in TP1) will be assessed. For selected organisms, ingested particles should be located and quantified by use of RAMAN-spectroscopy. The impacts of applied microplastic particles on relevant parameters (e.g. reproduction, population growth, development, life-span, activity) will be examined in chronic toxicity tests and linked to the previously defined ingestion rates. Following, more realistic and complex exposure scenarios will be simulated by use of natural and cultivated communities respectively in predator-prey-systems (e.g. with predatory copepods) or complex model-ecosystems (lentic and lotic). Within these assays, uptake and effects, in terms of alterations in the abundance and composition of the respective examined meio- and macrobenthic communities, will be assessed.
Duration
01.01.2018 - 31.12.2020
Reference Number
02WPL1448E